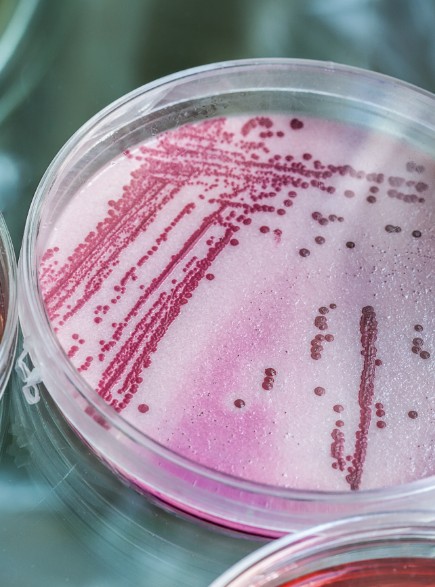

La nostra consulenza per le imprese

Corsi sulla sicurezza sul lavoro per aziende e professionisti
CHI SIAMO
Professionalità al tuo servizio
Da più di trent’anni supportiamo imprese e professionisti di diversi settori e dimensioni, fornendo consulenza e formazione in ambito sicurezza sul lavoro, igiene alimentare, qualità e sistemi di gestione aziendali, ambiente e privacy.

Proposte
Consulenza professionale alle imprese
Prossimi corsi
Le testimonianze
di chi ci ha scelto

"Le nostre esigenze sono alte e avevamo bisogno di un partner dello stesso livello. In Studio Essepi ho trovato una squadra che mi piace tanto, sono professionisti e abbiamo risultati migliori di quello che speravo".
Cristian Encher

“La crescita della nostra azienda ci ha portato all’adozione di nuove metodologie di lavoro e al coinvolgimento di consulenti in grado di dare un supporto per la formazione. Da Studio Essepi abbiamo ricevuto una grossa mano, con serietà, professionalità e competenza. Il punto di forza è il continuo aggiornamento”.
Maria Elena Zabotto

“La nostra azienda ha avuto una forte e rapida crescita in Italia, e il problema che abbiamo riscontrato con l’aumento della forza lavoro è sempre stato quello della formazione. Da quando abbiamo conosciuto Studio Essepi abbiamo risolto questo problema”.
Ivo Boscaini